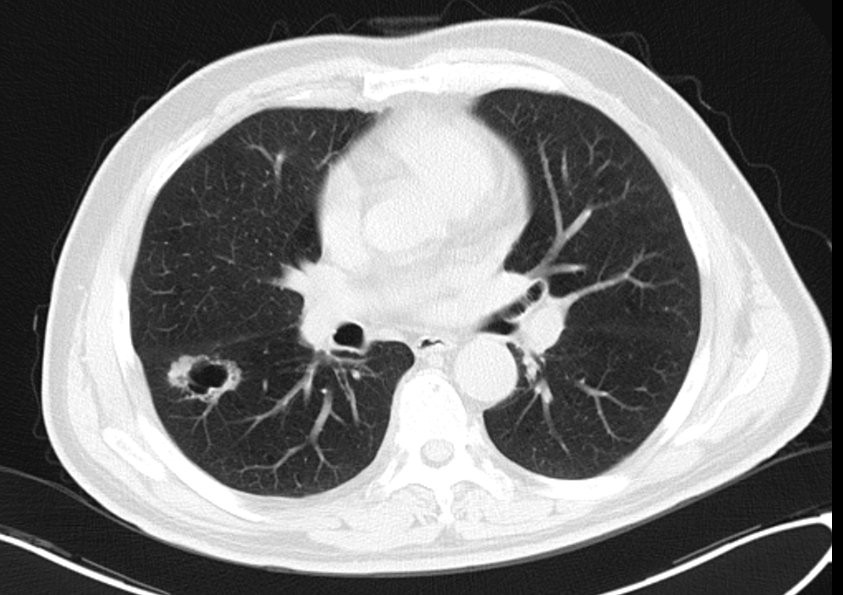
肺癌术后复发胸膜转移,肺癌术后复发转移还需要治疗吗

手术是肺癌患者最主要的根治性治疗手段之一,但患者在接受手术和辅助化疗后依然具有 较高的疾病复发和死亡风险,除IA期患者外,IB-III期的治愈率也并不乐观,IB/II/IIIA期的5年复发率分别是45%、62%、76%,依然有非常多的患者在手术后会发生复发或转移 。对于术后复发或转移性肺癌治疗,很多医患都认为可能是属于肺癌晚期了,治疗选择以晚期肺癌的治疗方案为主,其实不然…

肺癌术后出现复发或转移的治疗再选择
某男性,67岁,患者患者2015年11月起无明显诱因下出现间断轻咳,咳少量白痰,有时咳少量白色泡沫粘痰或黄色粘痰,无咯血,无胸闷胸痛,无气促不适,一直未在意。2016-05-08体检时发现肺部异常,在江苏省某医院肺CT检查,提示“右肺空洞”,后转入我院。
(2015年5月8日胸部CT提示右肺下叶背段空洞)
2016年6月3日在全麻下行单孔VATS右肺下叶切除术+肺癌根治术,手术顺利。术后病理:腺癌,右下叶18*9*2厘米,切面见一肿块,3.7x2.2cm,灰白灰黑色,界清,质中,局部近胸膜,距肺门2.5厘米。右下叶:浸润性腺癌(乳头型为主,伴实性型)。肿瘤表面胸膜:癌紧邻胸膜。神经浸润:未见明确神经浸润。脉管内癌栓:未见明确脉管内癌栓。支气管切缘:未见癌累及。第4组、第10组淋巴结未见转移。纤维脂肪组织,未见肿瘤累及。术后基因检测报告(2016-6-9):EGRR基因检测示Exon-21 L858R/L861Q 突变型、余均为野生型,KRAS、B-raf、ALK、ROS1、PIK3CA基因检测均为野生型。
术后诊断为右肺下叶浸润性腺癌p T2aN0M0-IB期,VATS右肺下叶切除术,Exon-21 L858R/L861Q 突变型。术后予以行GP4周期化疗(吉西他滨2.0d1、8,顺铂60mg d1、2)末次化疗时间为2016年10月9日。化疗结束后患者在家随访。
患者2018年2月出现咳嗽加重,2018-03-07 PET/CT检查报告:1、右肺癌术后,右肺门旁软组织伴肺门淋巴结FDG代谢异常增高灶(SUVmax=4.76),术后转移可能,建议随访。右残肺少许炎症。双肺气肿。2、脂肪肝,肝囊肿。3、右侧肾上腺腺瘤可能。4、前列腺增生。5、甲状腺术后。6、余全身(包括脑)PET显像未见FDG代谢明显异常增高灶。考虑右肺腺癌术后复发及肺门转移。

(2018年3月7日PET/CT提示右肺门旁软组织伴肺门淋巴结FDG代谢异常增高)
2018-3-30日入院患者入院后完善检查,行E-BUS检查,病理提示腺癌,基因检测提示L858R突变。诊断为,右肺中叶腺癌r T1bN1M0-IIB期,右肺下叶浸润性腺癌p T2aN0M0-IB期,VATS右肺下叶切除术后,患者家属考虑到既往已行右肺下叶切除术,且高龄,担心再次手术患者不能耐受,拒绝手术治疗。患者于2018-4-1日起行右肺腺癌术后肺门复发灶局部放疗,放疗计划剂量DT:60Gy/30Fx,同时行AC方案同步化疗,具体用药:培美曲赛0.98g ivgtt d1 +卡铂540mg ivgtt d1,q3w,放疗期间出现III度白细胞减少及II度血小板减少,予以升白细胞治疗及血小板治疗后好转,末次放疗时间为2018-5-16日。2018-6-15日及2018年7月18日行AC-T3-4周期化疗,术后予以定期随访。

(2018年5月20日胸部CT)

(2018年10月9日胸部CT见右肺中叶放疗后改变)

(2022年5月27日胸部CT提示病灶稳定)
对于II/III期肺癌患者,尽管接受根治性手术治疗,但仍然有不少患者仍会出现局部的复发或者远处转移的情况。对于这类患者,依据需要和手术前治疗一样,需要全面和仔细的检查。一部分患者通过检查,经胸外科医生评估后,仍然可能有再次手术的机会。对于一些不能手术的患者,仍可能可以接受包括立体定向放疗在内的根治性治疗手段,再辅以全身治疗手段,仍能达到再次根治性的治疗机会。而对这部分患者仅予以全身治疗,可能面临失去根治性治疗机会的风险。